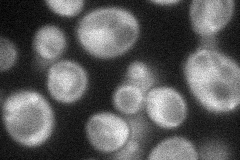

View description
Mitochondrial protein phosphatase of type 2C with similarity to mammalian PP1Ks; involved in mitophagy; null mutant is sensitive to rapamycin and has decreased phosphorylation of the Pda1 subunit of pyruvate dehydrogenase
Localization:
Intensity:
Fold change:
Significance:
-
C’ GFP library in SD

mitochondria20.04 -
N' NOP1pr-GFP in SD
cytosol40.2618 -
N' TEF2pr-mCherry in SD

cytosol22.2372 -
N' NATIVEpr-GFP in SD

below threshold21.8645 -
N' TEF2pr-VC and Cyto-VN in SD

below threshold27.3801 -
C’ GFP library in SD+DTT

mitochondria21.21.05No -
C’ GFP library in SD+H2O2

mitochondria19.80.98No -
C’ GFP library in Starvation Media

mitochondria19.040.95No -
C’ GFP library on the background of Pup2-DaMP

mitochondria -
C’ GFP library on the background of CCT mutant

mitochondria21.55771.07555No
